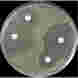
Müller Hinton, Agar, 10 stk

Resultater for Resistensbestemmelse ( 31 produkter )
Müller Hinton, Agar, 10 stk
Müller-Hinton agarplader til dyrkning og resistensbestemmelse af aerobe bakterier ved urinvejsinfektioner. Skal opbevares ved +2 til +7 °C og anvendes ved stuetemperatur.
112014